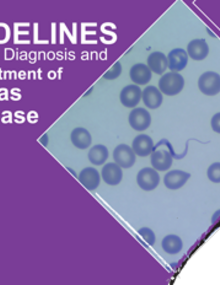
Guidelines for the diagnosis and treatment of Chagas disease

- Home
- Topics
- Countries
- Resources
- News
-
About
-
- Organizational Chart
- Statement of Assessed Contributions due from Member States
-
What We Do
- Communicable Disease Prevention, Control, and Elimination
- Comprehensive Immunization
- Evidence and Intelligence for Action in Health
- Innovation, Access to Medicines and Health Technologies
- Social and Environmental Determinants for Health Equity
- Health Emergencies
- Health Systems and Services
- Noncommunicable Diseases and Mental Health
- Partnerships
- Investigations Office
- Office of Internal Audit
-